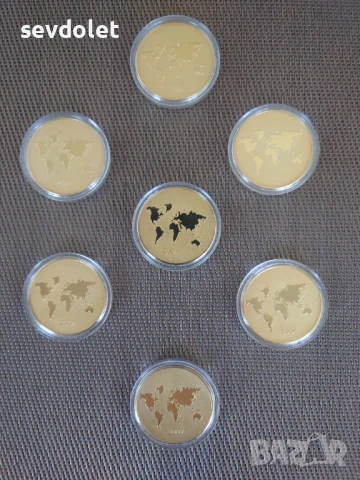
7те чудеса на светът.Цената е за всичките., снимка 3 - Колекции - 51424779

sevdolet
В Bazar.BG от 28 ноември 2022г.
Последно активен
днес в 06:40 ч.
7те чудеса на светът.Цената е за всичките. → Обява 51424779
7те чудеса на светът.Цената е за всичките.
Здравейте!
Предлагам Ви за продажба интересен ,колекционерски лот:
-Монети.
-Седемте чудеса на света.
-Позлатени.
-Нови.
Артикулите са без забележка(в отлично състояние).
Обявената цена е за всичките. Продават се и поотделно 9 евро /бр.
Разгледайте, ако желаете и имате свободно време и другите ми обяви. В тях ще намерите различни и много, антикварни монети, банкноти и други стилни предмета.
Благодаря!
Преглеждания: 169
Другите търсят също
Популярни търсения:
банкноти евро
Вход
Регистрация
Влез в профила си или се регистрирай, за да не губиш наблюдаваните обяви, търсенията си и следваните потребители – ще ги имаш навсякъде с теб.
Вход/Регистрация

![антикварна брошура за филмова програма от 60-те години на миналия век. ] Филм: Брошурата е за уестър](http://cdn8.focus.bg/bazar/38/pics/3842bfe678ef27076f53b63411d68dab.webp)




